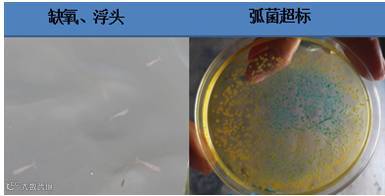

文 | 图 浙江海大 张慧
入了对虾养殖这个门,我们不仅要了解这尾虾,更要对各养殖阶段对虾养殖中常出现的问题以及引起这些问题的原因做到心里有数。
一、连续高温,养殖隐患已初现
七月份,连续的高温,虽然平稳度过,但是从养殖情况来看一些弊端已经埋下,8-9月更需要细心管理。
8-9月份养殖已经出现问题:
1、塘口水质已经老化,藻类死亡较多,水色浓而pH不够;
2、水体微量元素严重消耗,池塘水体不稳定;
3、弧菌繁殖,部分池塘弧菌超标;
4、池塘底部有机质积累,泛底,水分层等耗氧量大;
5、池塘对虾处于亚健康,肝胰脏受损,免疫力下降;
6、白便虽没有大量爆发,但是已经开始逐步增加。

图1 池塘隐患1
在池塘已经埋下隐患,白便等疫情开始出现,再加上台风等特殊天气情况多重影响下。如果管理不当会后续引发缺氧浮头、氨氮亚硝酸升高、白便爆发等养殖问题。


图2 池塘隐患2
二、台风、高温双夹击,如何预防和处理
接下去8-9月浙江地区对虾养殖,我们怎样做出预防和问题处理呢?
1、首先就是做好台风预防:台风经过时常伴随着大风和暴雨或特大暴雨等强对流天气,并且气压随着台风过境时出现由高到低,再到高的变化。随之造成养殖水体中溶氧的变化,溶氧的变化又会导致水体生态系统的波动变化,进而影响对虾养殖。
台风 |
气压 |
溶氧 |
过境前 |
高 |
高 |
过境中 |
低 |
低 |
过境后 |
高 |
高 |
图3 台风前后池塘溶氧变化
2、其次是留意高温:浙江区域每年高温期在7月中旬至8月中旬前后,持续1-2个月。高温对对虾养殖影响较大,表现为:
1、水温和溶氧饱和度成反比,高温期易造成缺氧;
2、凌晨溶氧低时,饲料投喂多,鱼多的池塘容易料比过高;
3、光照太强,藻类容易老化和死亡,造成pH值过高、倒藻等;
4、水温高,细菌生长快,菌相失衡时,弧菌易爆发;
5、虾子摄食欲望大增,投喂过多时,易造成消化负担。

图4 参考2016年萧山绍兴温度变化
3、再次是暴雨:突降大雨,水体受环境影响变化大,对虾养殖受影响。
1、长期暴雨应激,虾子连续应激时,易造成抽筋、软壳、偷死等;
2、雨水有害物质,如有害粉尘、有毒气体等,污染养殖水体;
3、突发暴雨,易造成泛底。


图5 暴雨天气
综上,接下去高温、台风暴雨都会对养殖造成严重危害,其中关键点都在于水体溶氧的降低。
三、养虾等于“氧虾”:
如何维持池塘溶氧收支平衡
养虾等于“氧虾”,本文针对“海大1+6养殖模式”中的足氧,结合7-8月养殖整理出关于溶氧管理建议。
1、对虾养殖正常要求溶氧不低于4ppm,在低于4ppm以下会对对虾养殖造成不利影响。

图6 养殖池塘溶氧量与对虾生长关系
2、溶解氧最高点和最低点:池塘水体溶解氧以下午2点前后最高,凌晨5点前后最低。

图7 养殖池塘溶氧曲线示例
3、目前市场上已经有出现浮头现象:因为池塘溶氧低导致对虾浮头,吃料慢、虾子不健康等情况。为此我们有做过定点溶氧监测:凌晨6点,亩投喂500斤虾塘溶氧多数低于3mg/l,有的池塘低于2 mg/l。

图8 2017年萧山区域6月25日池塘溶氧检测
4、池塘溶氧收支平衡:水产高密度养殖直接会造成平衡被打破,增氧往往跟不上氧气的消耗。


图9 养殖水体溶解氧收支平衡影响因素对比
所以,一方面增加溶氧,另一方面减少耗氧,才能保证养殖高产稳收!
四、养殖池塘8-9月保证溶氧管理措施
1、增氧机管理:例如1.5kw增氧机供800斤虾产量, 0.75KW增氧机供500斤产量。
2、化学增氧:例如用202,1包4-5亩,对于存塘量4-500斤以上池塘连续使用两次,晚上8点泼洒。
3、加换水:天气好时每天加水3-5公分,筛绢网过滤,最好是蓄水池及深井水。
4、改底:底脏,如黑泥、淤泥厚度大于2公分,投喂量达到300斤/亩以上,可以考虑用养底力士(1包3亩)+底倍爽(1包5亩),7天1次。
5、合理投喂,减少有机质积累:拌料虾多宝,1:4拌料,控料时间1小时以内;凌晨7点后投喂,下午5点,上午一餐可多于晚上一餐1/4。
6、降低密度:合理规划卖虾。
7、水质管理:通过“罗氏晒水”及PH检测对比,对倒藻等池塘进行肥水补钙镁管理;
8、应急处理:粒粒氧1包3亩,凌晨3-4点应急使用,配合502抗应激添加钾离子,维持渗透压,提高对虾耐低溶氧能力,若是倒藻,需要及时201解毒。
附:使用202增氧好效果对比
使用202池塘(33#及2#池塘),溶氧高于所测池塘溶氧平均值近2mg/l以上,如图12。

图10 使用海联科202溶氧检测对比
建议:合理规划卖虾
对虾养殖首先要求做到对自己的养殖有一个合理的规划,其实这一点很重要。虽然我们大多数人都能在放苗前规划清晰,但是在养殖过程中就会忘记。该卖虾时不舍得卖、水质好了就不做预防、看别人投喂的多了自己也要跟上等等都是造成功亏一篑的错误决定。

在一定条件下,你投喂增加的快慢与卖虾早晚成正相关,投喂的快是以降低对虾免疫力为前提的。所以如果想养殖大虾(20头以内),养殖时间长是一定的,同样的日投饵率就不能过多,要控料。反之,想早卖虾,可以在一定的条件下按标准增加投喂量,同样的,其它改底调水的投入相应也要增加。

这就是养殖规划,也是海大技术服务体系总结推广的养殖模式中最关键的系统环节。


